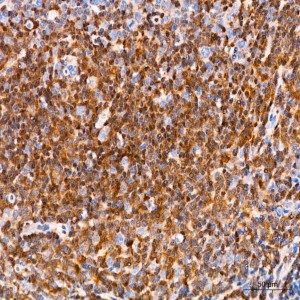
KO-Validated Smad3 Rabbit mAb (20 μl)

| Reactivity: | Human, Mouse, Rat |
| Applications: | WB, IHC, ELISA |
| Host Species: | Rabbit |
| Isotype: | IgG |
| Clonality: | Monoclonal antibody |
| Gene Name: | SMAD family member 3 |
| Gene Symbol: | SMAD3 |
| Synonyms: | LDS3; mad3; LDS1C; MADH3; JV15-2; hMAD-3; hSMAD3; HSPC193; HsT17436; d3 |
| Gene ID: | 4088 |
| UniProt ID: | P84022 |
| Clone ID: | 5W8U8 |
| Immunogen: | A synthetic peptide corresponding to a sequence within amino acids 100-200 of human Smad3 (NP_005893.1). |
| Dilution: | WB 1:20000-1:80000; IHC 1:200-1:2000 |
| Purification Method: | Affinity purification |
| Concentration: | 1.61 mg/ml |
| Buffer: | PBS with 0.05% proclin300, 0.05% BSA, 50% glycerol, pH7.3. |
| Storage: | Store at -20°C. Avoid freeze / thaw cycles. |
| Documents: | Manual-SMAD3 monoclonal antibody |
Background
The SMAD family of proteins are a group of intracellular signal transducer proteins similar to the gene products of the Drosophila gene 'mothers against decapentaplegic' (Mad) and the C. elegans gene Sma. The SMAD3 protein functions in the transforming growth factor-beta signaling pathway, and transmits signals from the cell surface to the nucleus, regulating gene activity and cell proliferation. This protein forms a complex with other SMAD proteins and binds DNA, functioning both as a transcription factor and tumor suppressor. Mutations in this gene are associated with aneurysms-osteoarthritis syndrome and Loeys-Dietz Syndrome 3.
Images
 | Western blot analysis of various lysates, using [KO Validated] Smad3 Rabbit mAb (A22133) at1:20000 dilution. Secondary antibody: HRP-conjugated Goat anti-Rabbit IgG (H+L) (AS014) at 1:10000 dilution. Lysates/proteins: 25μg per lane. Blocking buffer: 3% nonfat dry milk in TBST. Detection: ECL Basic Kit (RM00020). Exposure time: 30s. |
 | Western blot analysis of lysates from Rat testis, using [KO Validated] Smad3 Rabbit mAb (A22133) at1:20000 dilution. Secondary antibody: HRP-conjugated Goat anti-Rabbit IgG (H+L) (AS014) at 1:10000 dilution. Lysates/proteins: 25μg per lane. Blocking buffer: 3% nonfat dry milk in TBST. Detection: ECL Basic Kit (RM00020). Exposure time: 90s. |
 | Western blot analysis of lysates from wild type(WT) and Smad3 knockout (KO) HCT 116 cells, using [KO Validated] Smad3 Rabbit mAb (A22133) at1:20000 dilution. Secondary antibody: HRP-conjugated Goat anti-Rabbit IgG (H+L) (AS014) at 1:10000 dilution. Lysates/proteins: 25μg per lane. Blocking buffer: 3% nonfat dry milk in TBST. Detection: ECL Basic Kit (RM00020). Exposure time: 30s. |
 | Immunohistochemistry analysis of paraffin-embedded Human tonsil tissue using [KO Validated] Smad3 Rabbit mAb (A22133) at a dilution of 1:200 (40x lens). High pressure antigen retrieval performed with 0.01M Citrate Buffer (pH 6.0) prior to IHC staining. |
 | Immunohistochemistry analysis of paraffin-embedded Human kidney tissue using [KO Validated] Smad3 Rabbit mAb (A22133) at a dilution of 1:200 (40x lens). High pressure antigen retrieval performed with 0.01M Citrate Buffer (pH 6.0) prior to IHC staining. |
 | Immunohistochemistry analysis of paraffin-embedded Mouse kidney tissue using [KO Validated] Smad3 Rabbit mAb (A22133) at a dilution of 1:200 (40x lens). High pressure antigen retrieval performed with 0.01M Citrate Buffer (pH 6.0) prior to IHC staining. |
 | Immunohistochemistry analysis of paraffin-embedded Rat kidney tissue using [KO Validated] Smad3 Rabbit mAb (A22133) at a dilution of 1:200 (40x lens). High pressure antigen retrieval performed with 0.01M Citrate Buffer (pH 6.0) prior to IHC staining. |
You may also be interested in: